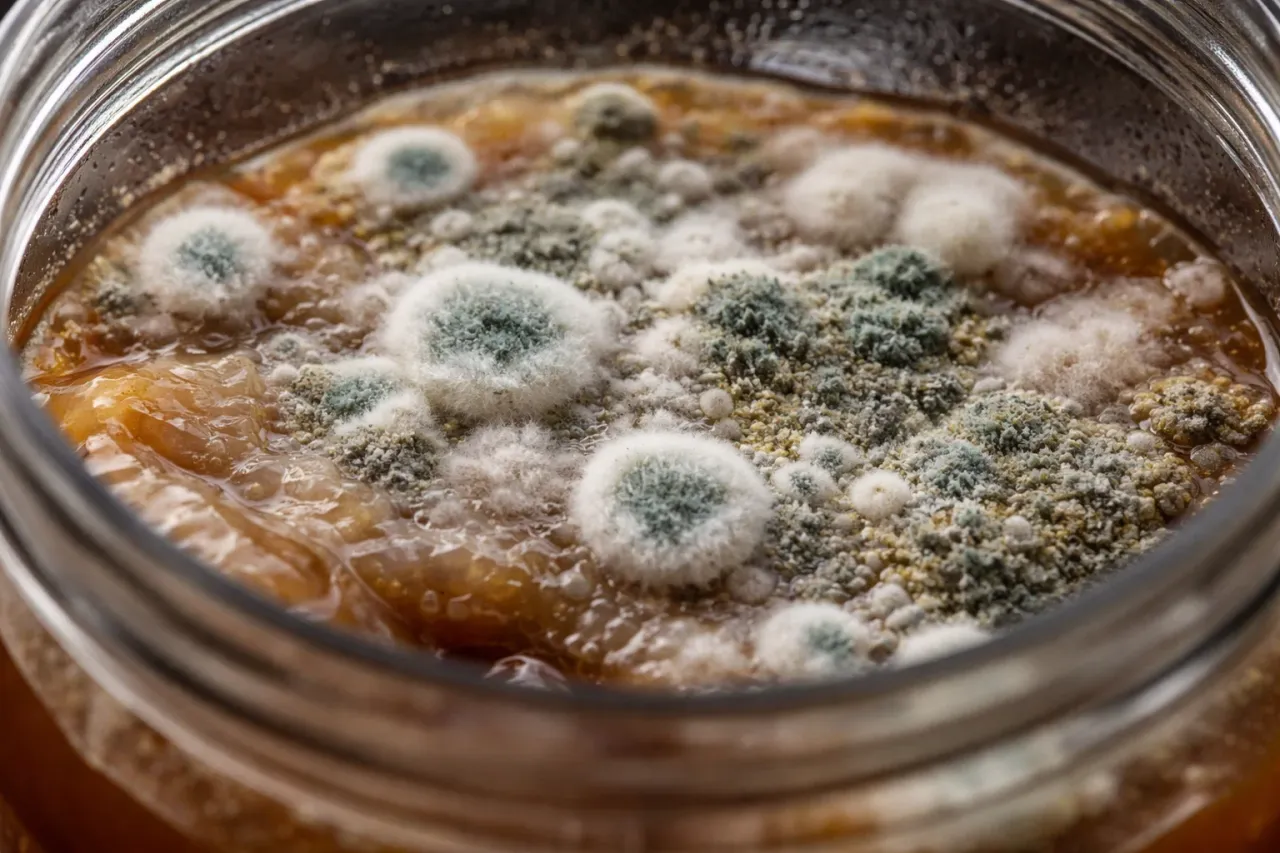
Objawy zakażenia warki: jak rozpoznać pleśń (białe, zielone kłaczki) a jak kożuch drożdżowy (gładki, błonkowaty nalot).

Napisanie pierwszego piwa w domu to ekscytujące doświadczenie, ale z czasem, gdy zaczynasz eksperymentować z nowymi stylami i metodami, możesz natknąć się na coś, co wzbudzi Twój niepokój. Widok dziwnych osadów, błon czy kolorowych plam na powierzchni fermentującego piwa potrafi przyprawić o szybsze bicie serca. Wiele osób w takiej sytuacji od razu zakłada najgorsze że warka jest zakażona i nadaje się do wylania. Chcę Cię uspokoić: nie każda anomalia w fermentorze to wyrok. Często to, co wydaje się groźną infekcją, jest w rzeczywistości zupełnie naturalnym zjawiskiem fermentacyjnym. Resztki piany, które powoli opadają na ścianki fermentora, skupiska drożdży tworzące na powierzchni luźne, beżowe lub brązowe osady to wszystko normalne procesy. Te zjawiska nie tworzą jednolitej, gęstej błony, co jest kluczową różnicą w porównaniu do faktycznych infekcji, o których zaraz opowiem.

Zauważyłeś coś dziwnego w fermentorze? Spokojnie, to nie musi być wyrok dla Twojego piwa
Wiele początkujących piwowarów domowych wpada w panikę, gdy tylko zauważy coś nietypowego w swoim fermentorze. Widok osadów, które nie przypominają typowego "kołnierzyka" drożdży na ściance, może budzić obawy. Chcę Cię uspokoić: nie każda anomalia w fermentorze to katastrofa. Często z infekcją mylone są normalne zjawiska fermentacyjne, takie jak resztki piany fermentacyjnej, które powoli opadają, czy skupiska drożdży osiadające na ściankach fermentora lub unoszące się na powierzchni. Te osady mają zazwyczaj beżowy lub brązowy kolor i nie tworzą jednolitej, gęstej błony, co odróżnia je od faktycznych infekcji. Jak podaje BeerFreak.pl, zrozumienie tych różnic jest kluczowe dla prawidłowej oceny sytuacji.
Pamiętaj, że fermentacja to dynamiczny proces, w którym drożdże pracują intensywnie, produkując alkohol i dwutlenek węgla. W jego trakcie mogą powstawać różne struktury, które na pierwszy rzut oka mogą wydawać się niepokojące. Ważne jest, aby zachować spokój i przyjrzeć się bliżej, zanim podejmie się jakiekolwiek drastyczne kroki.
Klucz do diagnozy: Jak odróżnić groźną pleśń od tajemniczego kożucha?
Kluczowe znaczenie w ocenie stanu Twojej warki ma prawidłowa diagnoza. Zrozumienie, czym różni się groźna pleśń od potencjalnie niegroźnego kożucha, pozwoli Ci podjąć właściwe kroki i uratować piwo, jeśli to możliwe, lub uniknąć spożycia czegoś, co mogłoby zaszkodzić Twojemu zdrowiu.
Wróg numer jeden piwowara: Jak bezbłędnie rozpoznać pleśń?
Pleśń to najpoważniejsze zagrożenie, jakie może spotkać piwowara domowego. Jest to organizm, który bezwzględnie dyskwalifikuje warkę do spożycia ze względu na potencjalną szkodliwość dla zdrowia. Jej obecność oznacza, że piwo jest zanieczyszczone i nie nadaje się do picia. Pleśń charakteryzuje się wyraźnie "włochatą", "puchatą" lub "kosmatą" strukturą, która unosi się na powierzchni piwa. Może przybierać różne kolory od białego, przez zielony, niebieski, aż po czarny. Pleśń rozwija się najczęściej w miejscach, gdzie ma dostęp do tlenu. Jeśli zauważysz na powierzchni swojego piwa takie objawy, nie wahaj się piwo należy bezwzględnie wylać.
Czym jest kożuch drożdżowy (pelikula)? Odkryj naturę dzikich drożdży i bakterii
Kożuch drożdżowy lub bakteryjny, nazywany również biofilmem lub pelikulą, to zjawisko, które często mylone jest z pleśnią. Jest to błona tworząca się na powierzchni piwa, będąca skupiskiem mikroorganizmów. Najczęściej są to dzikie drożdże, takie jak *Brettanomyces*, lub bakterie, na przykład z rodzajów *Lactobacillus*, *Pediococcus* czy *Acetobacter*. W przeciwieństwie do pleśni, kożuch jest zazwyczaj płaski i nie ma tej charakterystycznej "włochatej" struktury. Choć jego pojawienie się często jest objawem niezamierzonej infekcji, to w niektórych stylach piwnych, takich jak Lambic czy Flanders Red Ale, jest to efekt celowy i pożądany, nadający piwu specyficzne cechy smakowo-zapachowe.
Biały, płaski, pomarszczony – wizualny przewodnik po niegroźnych kożuchach
Kożuch drożdżowy lub bakteryjny może przybierać różne formy wizualne. Może być gładki, tworzyć delikatne zmarszczki na powierzchni, a czasem nawet bąbelki. Jego kolor to zazwyczaj odcienie bieli, szarości lub beżu. Piwo z takim kożuchem nie zawsze jest stracone. Jednakże, musisz być świadomy, że jego profil smakowy i zapachowy z pewnością ulegnie zmianie. Może stać się kwaśne, przypominając smak octu lub jogurtu, albo nabrać specyficznych, tzw. "funky" nut, które niektórzy piwowarzy określają jako zapach stajni lub końskiej derki. Warto ocenić, czy te zmiany są akceptowalne dla danego stylu piwa.
Kolorowe i "włochate" plamy – kiedy należy wylać warkę bez wahania?
Podsumowując, jeśli na powierzchni Twojego piwa dostrzeżesz kolorowe, "włochate" lub "puchate" plamy, które przypominają pleśń, jest to jednoznaczny sygnał, że warka jest zakażona i nie nadaje się do spożycia. W takich sytuacjach nie ma miejsca na eksperymenty. Ze względu na potencjalne ryzyko zdrowotne związane z rozwojem pleśni, najbezpieczniejszym i jedynym słusznym rozwiązaniem jest bezwzględne wylanie całej warki.
To nie pleśń ani kożuch? Poznaj innych nieproszonych gości w Twojej warce
Infekcje piwa domowego nie zawsze manifestują się wyłącznie wizualnie. Czasami to zapach i smak są pierwszymi sygnałami, że coś poszło nie tak. Warto wiedzieć, jak rozpoznać te subtelniejsze, ale równie ważne objawy, które mogą wskazywać na obecność niepożądanych mikroorganizmów w Twojej warce.
Kwaśne jak ocet lub jogurt: Kiedy za infekcję odpowiadają bakterie Acetobacter i Lactobacillus?
Wyraźnie kwaśny smak, przypominający ocet lub jogurt, to częsty objaw infekcji bakteryjnej. Bakterie takie jak *Acetobacter* i *Lactobacillus* potrafią wnieść do piwa niepożądaną kwasowość. Jeśli Twój trunek nagle nabrał takiego charakteru, a nie był to zamierzony cel (jak w przypadku niektórych kwaśnych piw), jest to silny sygnał alarmowy. W takich przypadkach profil smakowy piwa jest nieodwracalnie zmieniony i zazwyczaj nie nadaje się ono do dalszego spożycia.
Aromat stajni i końskiej derki: Czy dzikie drożdże Brettanomyces to zawsze zły znak?
Charakterystyczne aromaty "funky", takie jak zapach stajni, mokrej ziemi czy końskiej derki, są domeną dzikich drożdży z rodzaju *Brettanomyces*. W większości stylów piwnych są one uważane za wadę, ponieważ nadają piwu niepożądane nuty. Jednakże, w niektórych tradycyjnych stylach, takich jak belgijskie Lambiki czy Flanders Red Ale, te "dzikie" aromaty są celowo pożądane i stanowią integralną część profilu smakowo-zapachowego piwa. Kluczem jest świadomość, czy te nuty są zamierzone, czy też pojawiły się niechciany.
Oleiste "sznurki" w piwie: Czym jest i jak wygląda zakażenie Pediococcus?
Bakterie z rodzaju *Pediococcus* mogą powodować specyficzne problemy w piwie. Jednym z najbardziej charakterystycznych objawów ich obecności jest powstawanie oleistych, "sznurkowatych" struktur w płynie. Dodatkowo, piwo może stać się wyraźnie zmętnione. Jeśli zauważysz takie zjawisko, jest to niemal pewny znak infekcji bakteryjnej, która negatywnie wpłynie na jakość i smak Twojego piwa.
Zapach apteki lub bandaża – co oznaczają fenolowe nuty w Twoim piwie?
Nietypowe zapachy, które można określić jako apteczne, szpitalne, a czasem nawet intensywnie goździkowe (zwłaszcza w stylach, gdzie takie nuty nie są pożądane, np. w lagerach), mogą świadczyć o obecności fenoli. Fenolowe nuty w piwie często wskazują na infekcję, ale mogą być również wynikiem nieprawidłowej fermentacji lub użycia niewłaściwych szczepów drożdży. W większości przypadków są one uważane za wadę piwa.
Skąd wzięła się infekcja? Poznaj największe grzechy piwowara domowego
Zrozumienie przyczyn, które doprowadziły do zakażenia Twojej warki, jest kluczowe, aby uniknąć podobnych problemów w przyszłości. Większość infekcji piwowarskich ma swoje źródło w niedostatecznej higienie i błędach popełnianych na różnych etapach procesu warzenia. Przyjrzyjmy się najczęstszym winowajcom.
Dezynfekcja to podstawa: Dlaczego wszystko, co dotyka zimnej brzeczki, musi być sterylne?
To jest absolutnie fundamentalna zasada piwowarstwa domowego: wszystko, co ma kontakt z brzeczką po jej schłodzeniu, musi być idealnie czyste i zdezynfekowane. Zdecydowana większość zakażeń wynika właśnie z niedostatecznej higieny w tym krytycznym momencie. Po schłodzeniu brzeczka jest podatna na atak bakterii i dzikich drożdży, które mogą znajdować się na nieodpowiednio przygotowanym sprzęcie. Zaniedbanie dezynfekcji na tym etapie to prosta droga do zakażenia.
Ukryci winowajcy: Nieszczelny fermentor, stara woda w rurce i jakość surowców
Istnieje kilka innych, często pomijanych źródeł infekcji. Nieszczelny fermentor, który pozwala na dostęp tlenu i niepożądanych mikroorganizmów z otoczenia, jest jednym z nich. Również stara, stojąca woda w rurce fermentacyjnej może stać się siedliskiem bakterii, które następnie przedostaną się do piwa. Nie można też zapominać o jakości samych surowców słód, chmiel czy drożdże mogą być źródłem niepożądanych mikroorganizmów, jeśli nie są przechowywane lub pozyskiwane w odpowiednich warunkach.
Pośpiech i niedokładność – jak małe błędy prowadzą do wielkich katastrof
Piwowarstwo domowe wymaga cierpliwości i precyzji. Pośpiech, niedokładność i pomijanie drobnych, ale ważnych kroków w procesie warzenia mogą mieć katastrofalne skutki. Przykłady? Niedokładne płukanie sprzętu po dezynfekcji, co może pozostawić resztki środka dezynfekującego, które wpłyną na smak piwa, lub brak cierpliwości przy schładzaniu brzeczki, co zwiększa ryzyko infekcji. Każdy etap ma znaczenie.
Diagnoza postawiona – co dalej? Twój plan działania w przypadku zakażenia
Po przejściu przez proces diagnozy, nadszedł czas na podjęcie kluczowych decyzji. W zależności od tego, z jakim rodzajem "intruza" mamy do czynienia, nasze dalsze kroki mogą być różne. Od bezwzględnego wylania warki, po podjęcie próby jej uratowania i wyciągnięcia wniosków na przyszłość.
Kiedy decyzja jest prosta: Bezwzględne wskazania do wylania całej warki
Istnieją sytuacje, w których decyzja o wylaniu warki jest jedynym słusznym i bezpiecznym rozwiązaniem. Przede wszystkim, jeśli na powierzchni piwa pojawiła się pleśń niezależnie od jej koloru czy struktury jest to sygnał, że piwo jest zanieczyszczone i może być szkodliwe dla zdrowia. W takim przypadku nie ma sensu ryzykować. Wylej całą warkę i dokładnie zdezynfekuj cały używany sprzęt, aby zapobiec przeniesieniu zakażenia na kolejne partie piwa.
Czy to piwo da się uratować? Kiedy warto dać szansę zakażonej warce
Jeśli Twoje piwo pokrywa jedynie kożuch drożdżowy lub bakteryjny (pelikula), a nie pleśń, istnieje szansa, że warkę uda się uratować. Jak już wspominałem, piwo z takim kożuchem nie zawsze jest stracone, ale jego profil smakowy i zapachowy z pewnością ulegnie zmianie. Może stać się kwaśne lub nabrać nut "funky". Warto spróbować uratować takie piwo, jeśli jesteś otwarty na eksperymenty smakowe i nie pojawiają się żadne oznaki pleśni. Pamiętaj jednak, że smak może być zaskakujący i niekoniecznie zgodny z pierwotnym zamierzeniem.
Przeczytaj również: Ile godzin po piwie można jechać samochodem bez ryzyka?
Jak uniknąć problemów w przyszłości? Proste kroki do idealnie czystej fermentacji
Najlepszym sposobem na radzenie sobie z infekcjami jest ich zapobieganie. Oto kilka prostych, ale niezwykle skutecznych kroków, które pomogą Ci utrzymać czystość i uniknąć problemów w przyszłości:
- Rygorystyczna dezynfekcja: To podstawa. Pamiętaj, aby dokładnie dezynfekować cały sprzęt, który ma kontakt z zimną brzeczką fermentor, węże, łyżki, a nawet butelki.
- Kontrola szczelności: Regularnie sprawdzaj szczelność swojego fermentora. Upewnij się, że uszczelki są w dobrym stanie. Dbaj o czystość rurki fermentacyjnej i używaj w niej świeżej wody lub roztworu dezynfekującego.
- Wysokiej jakości surowce: Używaj świeżych i sprawdzonych surowców. Kupuj słód, chmiel i drożdże od renomowanych dostawców.
- Dokładność i cierpliwość: Przestrzegaj procedur warzenia i daj piwu czas na fermentację. Pośpiech i niedokładność to częste przyczyny problemów.
